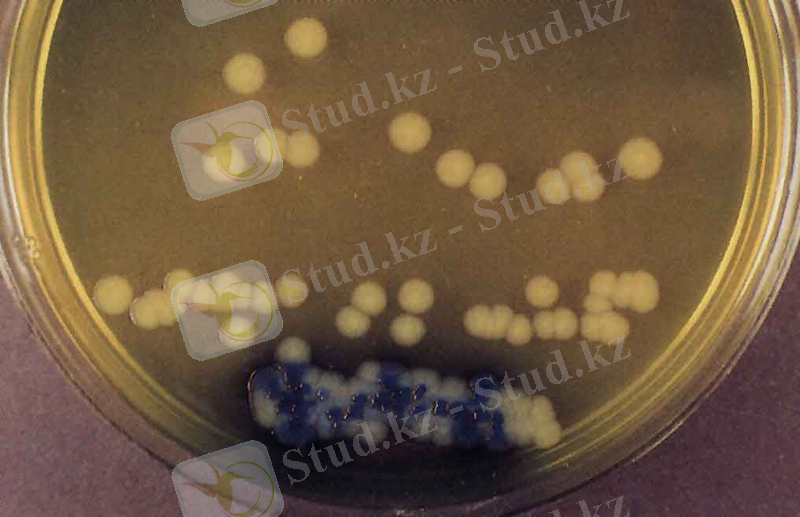
http://nsau.edu.ru/images/vetfac/images/ebooks/microbiology/stu/micro/pict/salmonell_l.jpg

Үй малдарының төлдеріндегі сальмонеллездің қоздырғышы, патогенезі және клиникалық-патологоанатомиялық ерекшеліктері


КІРІСПЕ
Қазіргі уақытта қоздырғыштары бактериялар, вирустар мен қарапайымдар, сонымен қатар бактериялардың токсиндері (бұл жағдайда диареяны бактериялардың өздері емес, қоздырғыш көбейген тағам өнімдерімен ас қорыту жолына түскен токсиндер тудырады) болатын 30-дан аса нозологиялық формалар белгілі.
Сальмонеллез ауруы жануарлар мен адамдар арасында болатын жіті ішек ауруы, көп жағдайларда азық-түлік арқылы беріліп, асқазан-ішек жолдарының зақымдалуымен сипатталатын бактерия тудыратын ауру. Біздің облыста жыл сайын 150-ден 200-ге дейін оқиғалар тіркеледі. Бүкіл әлемде 10 миллиондаған адам ауырып, жүз мыңдаған адам өлімге ұшырап жатыр. Қазіргі күнде Salmonella бактерияларының 2500-ден астам штамдары кездеседі.
Сальмонеллездер, оның ішінде, сальмонеллезді гастероэнтериттер бүкіл әлемде көптеп тараған; олар адамдардан басқа сүтқоректілерде, құстарда, қосмекенділерде де кездеседі. Бұл аурумен үй жануарлардың ауыруы ауыр экономикалық шығын әкеледі. АҚШ тұрғындары арасында 1 жылдың ішінде сальмонеллезбен ауырған 2 млн. астам адам тіркелген.
АҚШ-да сальмонеллез ауруынан шыққан экономикалық шығын - 2 млрд. долларға бағаланып отыр, ал Канадада -300 млн. ТМД елдерінде соңғы 15 жылда адамдар мен құстар сальмонеллезі 7 есеге көбейіп отыр, оның ішінде этиологиясы S. Enteritidis болатын адам ауруы 30%, құстардыкі - 75% өсіп отыр. Азық-түлік өнімдерінде қоздырғыштардың болуы - 50%-ға өскен. Сондықтан Қазақстан Республикасының жоғары білімді мамандарының міндеттері мен мақсатары ол қандайда болмасын ауыл шаруашылық салаларында жұмыс атқарғанда малдәрігерлік ісін ұйымдастыру жұмыстарын дұрыс жоспарлау, малдардың өсуін, құнын жоғарлату қандай да болмасын аурудан сақтау болып табылады.
Соған сәйкес, бұл курстық жұмысымның мақсаты - елімізде бұл індеттік аурудың торайларда өту патогенезін, патологиялық-анатомиялық өзгерістерін, індеттік ерекшеліктерін талдай отырып, келешекте сальмонеллездің мүлдем жойылуын көздейді.
ІІ НЕГІЗГІ БӨЛІМ
2. 1. Тарихи деректер.
ХХ ғасырдың 70 жылдарына дейін сальмонеллездарды тағамдық токсикоинфекцияларға жатқызылып келді. Одан ары қарай жеке нозологиялық формалы ауру болып белгіленді.
А. Боллингер және басқа да ғалымдар әр түрлі тағамдық уланулар септико-пиемиялық аурулармен ауырған жануарлар етінен болатындығын байқай бастады.
1885 жылы американдық зерттеуші Смит (Th. Smith) обамен ауырған шошқаның ішкі органдарын зерттей келе, suipestifer (Salmonella cholera suis) бактериясын тапты. Оның морфологиялық және биохимиялық қасиеттерін зерттеді. Ашылу туралы хабар Сальмон және Смитпен жарияланды.
1888 жылы Гертнер (G. Gaerther) «еттен уланған» адамның мүшелерінен және уланған адамдар қолданған еттен B. Enteritidis Gartneri бактериясын тапты. Микроб қасиеттері бойынша B. suipestifer-ға ұқсас болғандықтан және оны тапқан ғалымның атына сәйкес Гертнер таяқшасы деп аталды. «Еттік уланулардың» жаңа қоздырушылары ашылуы жалғаса берді. 1892 жылы Леффлер ауру тышқандардың етінен микробтар тапты, оларды B. typhimurium деп атады. Егеуқұйрықтардан 1893жылы Даниш, В. Н. Исаченко 1897 жылы, балапандар мен тауықтардан Реттчер 1900 жылы анықтады.
1900 жылы француз зерттеушісі Ж. Линьер, Сальмон мен Смит сипаттаған бактерияларды сальмонеллалар деп атауға ұсыныс жасады.
1934 жылы Халықаралық номенклатуралық комиссия бұл бактериялар тобын «сальмонеллалар», ал сальмонеллалар туғызатын ауруларды «сальмонеллез» деп атауға ресми шешім қабылдады. 1926 жылы А. В. Синев пен С. К. Беззубец қозылардан, қойлардан 1929 жылы П. В. Тавельский, шошқалардан - А. П. Уранов (1929ж. ), Н. А. Михин (1934 ж. ) и П. Н. Андреев (1937 ж. ) бөліп алды. Аурудың ескі атауы - паратиф, қазақша байырғы аты - қылау.
2. 2. Қоздырушысы мен төзімділігі
Сальмонеллез қоздырғыштары - Salmonella тұқымына кіреді. Enterobacteriaceae туыстығына жатады. Бұл тұқым 2017 серологиялық варианттардан тұрады. Ол тұқымдастар 52 серотопқа біріккен және әрқайсысының өзінің аттары бар. Олардың ішінен патогенділеріне: Salmonella enteritidis, Salmonella cholerasuis, Salmonella typhisuis, Salmonella typhimurium, Salmonella abortusequi, Salmonella abortusovis, Salmonella pullorum (gallinarium) жатады.
Сальмонелла төлдердің сепсисті түрде өтетін жұқпалы ауруы. Ауруға 3-4 апталықтан бастап 4 айлық жасқа дейінгі бұзаулар, 4айға дейінгі торайлар, барлық жастағы қойлар (қойлар іш тастайды), құлындар құрсақта жатқанда (сол себептен биелер іш тастайды), құстардың эмбриондары жаңа шыққан балапандары шалдығады. Бұл ауру кезінде бұзаулардың іші өтеді және безгек байқалады. Ал ересек малдар мен құстарда ешқандай белгілері байқалмай, ұзақ уақыт бойы бактерия тасымалдаушы болады.
Сальмонеллаларды бір-бірінен ажырату үшін олардың өсінділік, биохимиялық және антигендік қасиеттері зерттеледі.
Микроскопиясы. Органдардың ұлпаларынан жасалған жағындыларды Грам тәсілімен бояйды, сонымен қатар қысылған және аспа тамшы препаратында олардың жылжымалығын тексереді. Сальмонеллалар таяқша тәрізді, жеке-жеке кейде қос-қостан орналасады, көлемі 2-4мкм, грам-теріс, спора және капсула түзбейді, Salmonella pullorum (gallinarium) -нан басқалары жылжымалы (перитрихтер) .


1-сурет. Salmonella cholerasuis қоздырғыштары
Өсінділік қасиеттері .
Сальмонеллалар - аэробты және факультативті анаэробтарға жатады. Қолайлы өсу температурасы 37ºС, оңтайлы рН 7, 0-7, 2, дегенмен рН 7, 0-ден төменгі және 8, 0-ден жоғары орталарда да өсе алады. ЕПА, ЕПС, Эндо, Левин, Плоскирев, висмут-сульфитті агарында және т. б. жақсы өседі. Қарапайым қоректік орталарда, рН 7, 2-7, 6 37 С температурада өседі. Сұйық қоректік ортада (ЕПА) лайланған, ақ-сұр кілегейлі тұнба түзеді. Бетінде нәзік, араластырғанда тез бұзылатын қабық түзеді. Ет пептонды агар бетінде диаметрі 1-5мм кө кшіл-сұр колониялар түзіледі.

2 - сурет. Ет-пептонды агар қоректік ортасындағы Salmonella колониялары
ЕПА-да диаметрі 1-4 мкм аралығындағы кішірек, дөңгелек, шеттері тегіс, көкшілдеу реңді болып келген сұрғылт-ақ түсті колонияларды қалыптастырады (2-сурет) . Эндо қоректік ортасында мөлдір, қызғылт түсті, колонияларды, Левин ортасында - көгілдірлеу реңді мөлдір колонияларды, Плоскирев ортасында - түссіз, тығыз, сәл лайланған колонияларды, висмут-сульфитті агар беткейінде жылтыр реңді қара түсті колонияларды түзеді. ЕПС - біркелкі лайланады, шыны түтік түбінде сұрғылт-ақ түсті тұнбаны, кейде ортаның беткейінде жұқа қабықшаны немесе шыны түтік айналасында сақинаны қалыптастырады.
Биохимиялық қасиеттері . Сальмонеллалар сахарозаны бөлшектей алмайды, лактоза мен адонитті ыдыратпайды, салицин мен мочевинаны бұзбайды, индол түзбейді, күкіртсутекті бөліп шығарады, Фогес-Проскауэр реакциясында теріс нәтиже (орта сары түсті болады), ал метиленді қызыл реакциясында оң нәтиже көрсетеді. Сальмонеллалардың барлық типтері газды түзе отыра глюкозаны ыдырататын болса, кейбір штамдары: Salmonella typhimurium , Salmonella typhisuis , Salmonella abortusegui , Salmonella dublin , Salmonella anatum және Salmonella gallinarum глюкозаны газды түзбей ақ бөлшектейтін қасиетті иеленген. Сальмонеллалардың басым көпшілігінің биохимиялық қасиеттері тұрақсыз болып келетіндігін ескере кеткен жөн.
Антигендік құрылымы . Сальмонеллалардың соматикалық немесе О -антигені және жіпшелік немесе Н -антигені болады.
О -антиген микроб жасушасының беткейінде орналасқан, олар термостабильді фосфолипидті-полисахаридті кешеннен тұрады, қайнатқан жағдайда 2 сағатқа дейін бұзылмайды.
Н -антигендерінің сальмонеллалардың белгілі бір түрі мен типіне тән қасиеттерді иеленген (бірінші фазадағы антигендер) және телімділік қасиетті иеленбеген (екінші фазадағы антигендер) түрлері болады. Екі фазадағы антигендері бар салмонеллаларды екі фазалы, ал жалқыларын бір фазалы деп атайды.
Соматикалық немесе О -антигендерінің негізінде сальмонеллалар 14 негізгі серологиялық топтарға біріктіріліп, олар латын алфавитінің бас әріптерімен белгіленеді ( A , B , C , D , т. б. ) . Бірінші фазадағы Н -антигендер латын алфавитінің кіші әріптерімен таңбаланса ( a , b , c , d , т. б. ), екінші фазадағы Н -антигендер араб цифрларымен таңбаланады (1, 2, 5, 6, т. б. ) . Зертханаларда сальмонеллалардың О - және Н -антигендеріне талдау жасай отыра, олардың серологиялық топтарын анықтау Куфман - Уайттың диагностикалық схемасы бойынша жүргізіледі. Сальмонеллалардың серологиялық варианттарын анықтауға арналған поливалентті және моновалентті О -қан сарысулары мен монорецепторлы Н -қан сарысуларын шыны беткейінде қойылатын агглютинация реакциясы қолданылады.
Төзімділігі . Сальмонеллалар қоршаған орта әсерлеріне төзімді келеді. +60°С температурада 1 сағатта, +100°С-де бірден тіршілігін жояды. Топырақта және қоршаған ортаның басқа да нысандарында - 30-270 тәулікке дейін, өлекселерде - 100 тәулікке, ашық су қоймалары ішетін суда - 11-120 тәулікке, мұздатылған етте - 60-130 тәулікке, жұмыртқада - 13 айға, жұмыртқа ұнтағында - 9 айға, мұздатылған жеміс-жидектерде 2 аптадан 2, 5 айға дейін сақталады. Тікелей түскен күн сәулесінің әсерінен олар 5-9 сағатта жойылады. Сальмонеллалар сыртқы ортада қолайлы жағдай туса, көбейе береді. Олар ет-шұжық, сары майда 4 айға, сүтте 20 күнге, ірімшікте 1 жылға дейін тіршілігін жоймайды. Малға беретін жемдерде 10 ай, топырақта 18 айға дейін сақталады. . Дезинфекциялағыш заттар (2 %-ды натрий сілтісі, 2 %-ды хлорлы әк, 2 %-ды формальдегид ерітінділері) сальмонеллаларды 15-20 минут аралығында өлтіреді. Сальмонеллалардың гентамицин, неомицин, тетрациклин, левомицетин мен стрептомицинге сезімталдығы жоғары, ал сульфаниламидті және нитрофуранды препараттарға төзімді болып келеді. Сальмонеллар - негізінен көптеген жабайы және үй жануарларының ішек жолының қалыпты микрофлорасы болып келеді.
Серологиялық типтерін анықтау . Сальмонеллалардың патологиялық материалдардан бөлініп алынған өсінділері сальмонеллездің поливалентті агглютинациялаушы О-қан сарысуының көмегімен, зат шынысының бетіндегі Агглютинация реакциясында анықталады. Оң нәтиже көрсеткен өсінді әртүрлі монорецепторлы О-қан сарысуларымен тексеріледі. Сонан соң өсінділер монорецепторлық Н-қан сарысуларымен зерттеледі. Сонымен қатар иммунды флюоресценция реакциясы сальмонеллалардың серологиялық О-топтарын ( А, В, С1, Д1) бір-бірінен ажыратуда қолданылады.
Бұзау сальмонеллезінің қоздырғышы - Salmonella enteritidis. Антигендік құрылымы жағынан «Д» тобына жатады. Ақ тышқандар үшін патогенді. Кейде бұзау сальмонеллезін Salmonella typhimurium қоздырады. Бұл суда жүзетін құстардың және адамның сальмонеллезін де қоздырады. Антигендік қасиеті жағынан « В » тобына жатады.
Торай сальмонеллезінің қоздырғышы - Salmonella typhisuis немесе Salmonella cholerasuis. Олар адамның тамақ арқылы улануын тудырады. О-антигенінің құрылымы жағынан « С » тобына жатады. «Д1» серо
Бие сальмонеллезінің қоздырғышы - Salmonella abortusequi. Сальмонеллезге шалдыққан биелер іш тастайды. Жылқылар агглютинация реакциясымен тексеріледі. АР-ның оң нәтижесі ретінде қан сарысуының 1:400 және одан да жоғары титрлері алынады. О - антигені бойынша «В» тобының сальмонеллаларына жатқызылады.
Қой сальмонеллезінің қоздырғышы - Salmonella abortusovis. О-антигені бойынша сальмонеллалардың «В» тобына жатады.
Құс сальмонеллезінің қоздырғышы - Salmonella pullorum (gallinarium) . Антигендік қасиеттері жағынан «Д1» тобына кіреді. Сальмонелез (пуллороз) жедел түрде, сепсисті формада өтетін жұқпалы ауру. Ауруға шалдыққан бір апталық балапандар мен эмбриондардың 100%-ға дейін өледі. Лабороторияға бірнеше балапандардың өлексесі жіберіледі. Ересек құстардың қан сарысуларын қанды-тамшылы агглютинация реакциясымен тексеру үшін пуллороз антигенімен сенсибилизацияланған эритроциттерді қолданады.
2. 3. Індеттік ерекшеліктері.
Ауруға 3-4 апталықтан бастап 4 айлық жасқа дейінгі бұзаулар, қозылар 3-20 күндігінде жиі ауырады, барлық жастағы қойлар (қойлар іш тастайды), құлындар құрсақта жатқанда (сол себептен биелер іш тастайды), құстардың эмбриондары жаңа шыққан балапандары шалдығады. Бұл ауру кезінде бұзаулардың іші өтеді және безгек байқалады. Көбінесе ауруға 5 айға дейінгі торайлар ауырады, емшектегі торайларда сирек кездеседі. Энзоотия сипатында өтеді. Маусымдылық байқалмайды. Жас торайлар арасында шығын 10-90% аралығында болады. Ауру септициямен, жіті немесе созылмалы энтеритпен сипатталады.
Сальмонелла микробы малға асқазан-ішек жолдары арқылы енеді. Ауруға әдетте күтімі нашарлаған мал бірінші ұшырайды. Егер фермада жас торайлардың арасында біреуі ауырса, ол сыртқы ортаға нәжісімен бірге көптеп микроб шығарады, сөйтіп басқа торайларға жұғады.
Буаз саулықтардың арасында төлдеу науқаны басталардан 30-45 күн бұрын паратиф ауруының шығуы мүмкін. Бұл аурудың бір шыққан жерінен келесі жылы тағы да шығуы мүмкін. Себебі ол малдың қиында, суда, топырақта ұзақ уақыт сақталады.
Жас құлындар арасында да бұл ауру жиі кезедеседі. Сальмонеллез ауруының шығуына бірнеше жағдай әсер етеді. Айталық, буаз сиырлардың, саулықтардың және биелердің қыс, көктем айларында күтімінің нашарлауы, олардың сапасыз азықпен азықтандырылуы, күнделікті мал рационының құрамында витамин және минералды заттардың жетіспеуі т. б.
Қоздырушылары - Salmonella cholera suis пен Salmonella typhi suis, сирегірек - Salmonella typhimurium мен Salmonella dublin, т. б.
Үйрек пен көгершін жиі, сирегірек тауық, күркетауық және қаз ауырады. Үй құстарының 6-20күндік балапандары сезімтал болады да, ауру жіті өтеді. 2, 5айдан асқанда созылмалы, ал ересек құста симптомсыз немесе жыныс мүшелерінің шектеулі зақымдануы ретінде өтеді. Инфекция қоздырушысының бастауы - ауру немесе сальмонелла алып жүретін құстар. Олардың жұмыртқалары, зарарланған жем, су, құрал-жабдықтар жұғу факторлары болып табылады. Микроб трансовариальдік және алиментарлық жолмен беріледі. Індет ошағы әдетте тұрақты сипат алып, ауру құстың күтімі нашарлаған кезде қайтадан өрлейді.
Шаруашылық үшін бұл ауру үлкен зиянын тигізеді. Мәселен, сальмонеллезге, яғни қылауға шалдыққан саулықтардың 60-70 проценті, биелердің 40-50 проценті іш тастайды. Сонымен қатар, бұзаулардың 30-40 проценті, ал жаңа туған торайлар мен қозылардың 20-40 проценті өлім-жітімге ұшырайды.
2. 4. Дерттенуі мен патогенезі.
Сальмонеллалардың патогендік қасиеттері, олардың түзетін экзотоксиндері мен эндотоксиндеріне байланысты болып келеді. Экзотоксиндер бактериялардың тіршілік етуі барысында қоршаған ортаға қарқынды бөлініп отырады. Эндотоксин микроб жасушалары өлгеннен кейін лизиске ұшырауының нәтижесінде пайда болады. Сальмонелла эндотоксиндерінің молекуласы полисахаридтер мен А-липидінен тұрады. Эндотоксиндер ішектің геморрагиялық қабынуын тудырады және шошқалар мен ет қоректілердің азықтық улануына әкеліп соқтырады
Ауру қоздырғышы азық арқылы ішекке түседі де, тез көбейіп, өніп өседі, қанға енеді. Бактериялардың токсиндері (бактеремия) микроциркуляторлық тамырлар қабырғаларын зардаптап, эндотелиоциттерді бүлдіреді, қанның ұйысу факторларының белсенділігін арттырады. Нәтижесінде майда тамырлар кеңійіп, қан ағысы баяулайды, бауыр, талақ, бүйрек т. б мүшелердің майда қан тамырларында көптеген шашыранды қан ұйыстары (микротромбтар) мен стаз туындайды, паренхималық мүшелер дистрофияға ұшырайды, қанталаулар пайда болады. Некроз ошақтары бауырда, талақта, бүйректе, өкпеде және буындарда кездеседі. Өлімнің тікелей себебі - жіті сепсистік (токсиндік - инфекциялық) шок. Ересек малдарда ауру белгілері байқалмаса да, оларда бактерия алып жүрушілік болады, сүтке, нәжіске ілесіп мал денесінен сыртқа шығады. Мұндай малдар аурудың шығу және жұғу көздері болып есептеледі. Буаз малдарда (саулық, бие) қоздырушы жатырға, плацентаға, шаранаға еніп, қабыну процестерін шақырып, іш тастауға әкеледі.
Жануарларда ауру ағымы негізгі және қосымша сальмонеллез, бактерия тасымалдаушы деп бөлінеді. Негізгі сальмонеллезді жануарлардың белгілі бір түріне жататын сальмонеллалардың серологиялық варианттары тудырады. Қосымша сальмонеллез негізгі ауруға қосылып, оны асқындырып жібереді. Мұндай жағдайда сальмонеллезге тән белгілер нашар байқалады. Мысалы, егер Сальмонеллез диплококкозбен асқынса, төлдердің буындары қабынып, анкилоз дамиды.
Бактерия тасымалдаушылар клиникалық жағынан сау жануарлар қатарына жатқызылғанымен, олар сыртқы ортаға сальмонеллаларды нәжісі мен зәрі арқылы таратушы болып саналады. Олар тек төлдерге ғана қауіп төндіріп қана қоймай, өнімдері арқылы адамдардың да улануына әкеледі
Сальмонеллаларды алып жүру жануарлар арасында кең таралған. Ересек жануарлардың көпшілігінің организмінде, мал қораларында бұл микроб жиі кездеседі. Аурудың қаулауы көбінесе шаруашылықтағы малдың резистенттілігін әлсірететін бағып-күтудегі, азықтандырудағы ақауларға байланысты болады.
2. 5. Өтуі мен симптомдары.
Ауру жіті, жітілеу және созылмалы түрде өтеді. Еметін торайларда көбінесе - жіті түрде, ал енесінен айырған торайларда - жітілеу және созылмалы түрде өтеді.
Жасырын кезеңі 10-20 күнге созылады. Еметін торайларда бұл кезең қысқа.


3-сурет. Сальмонеллез ауруы кезіндегі клиникалық белгілер
Жіті кезеңі дене температурасының 41-42 С көтерілуімен, еметін торайларда сору рефлексінің жоқтығымен және ересек торайларда азықтан бас тартуымен сипатталады. Ауру жануарлардың тынысы тереңдейді, іші өтеді. Кейбір жануарларда құсу байқалады және конъюктивит дамиды. Аурудың өршуі барысында торайлар азықтан қалады. Артқы аяқтарын бүгіп, алдыңғы аяқтарын созып жатады, себебі шаншу тәрізді аурулар байқалады. Өлерден біраз уақыт бұрын торайлардың құлақтарында, құрсақ қуысында, ішінде терісінің көгергені (цианоз) байқалады. Аурудың 4-7 күнінде торайлардың 50-80% өлімге ұшырайды. Еметін торайларларда ауру қатты білінген іш өтумен, нәжісі сұйылады және түсі шымқай сары болып, көпіршікеніп білінеді. Септицемия дамымайды.
Егер ауру малды дер кезінде қан сарысуымен және күшті антибиотиктермен дұрыс емдеп, оның күтімін жақсартса, денесінің қызуы төмендеп, ас қорытуы, жалпы күйі оңалады да, 11-15 күнде қатаға қосылады.
Жітілеу кезеңінде ауру жіті кезеңдегідей дамиды, бірақ белгілері әлсіз білінген болады. 15-20 күнге созылады. Жануар жиі және ауыр тыныстайды, әлсіздік білінеді, кейбір торайлар азықтан бас тартады. Іш өту пайда болады, кейбіреулерінде өте жиі өтеді, кейбірінде іш қатумен алмасып отырады. Ауру жануарлар арықтайды, терілері сұрлана бастайды да жиырылып жиырылып аралары кірге толып қалады. Кейбір торайларда пневмония дамиды. Жітілеу кезеңде торайладың 40%-ы өледі. Резистенттілігі жоғары жануарлар жазылып кетеді.
Созылмалы түрде клиникалық белгілері өте әлсіз білінеді және ауру ұзаққа созылады. Ас қорыту органдарының зақымдану белгілері азаяды, тәбет пайда болады, бірақ тыныс алу органдарының зақымдану симптомдары күшейеді, бронхопневмония дамиды. Буындар қабынуы мүмкін ( бақай, тізе, тілерсек) . Ауру бірнеше аптадан 3 немесе одан да көп айға дейін созыла береді. Ауру мал қатты арықтайды, әлсірейді, жөтелі күшейе түседі, жата береді. Ем жасамау малды 50 процентке дейін өлімге жеткізеді.
Лебедевтың айтуынша: « Сальмонеллездің созылмалы түрінде өкпе зақымдалады. Серозды катаральды - лобарлы пневмония дамиды. Бара бара өкпе паренхимасына және тыныс жолына түскен микробтан іріңді - катаральды процеске ауысады. Өкпеде крупозды пневмония дамиды. Плеврит перикардитпен асқынады. Егер сальмонеллез диплококкозбен асқынса, төлдердің буындары қабынып, анкилоз дамиды».
Ауру жануардан: іштің қатуымен алмасып отыратын іш өту, қысқа уақытқа дене температурасы көтеріледі, тыныс алуы жиілейді. Конъюктивит байқалады және дене терісі бөрітіп кетеді.
Ересек шошқаларда сальмонеллез созылмалы түрде және жиі симптомсыз өтеді, тек ілеуде-бір (әсіресе буаз кезінде) асқыну байқалады: қысқа мерзімді қызу, іш тастау мүмкіндігі, өмір сүргіштігі жоқ төл тууы, мегежіндердің сүт аздығы болуы мүмкін. Ауру 5-8 күн жануардың жазылып кетуімен өтеді. Жануарлардың бір бөлігі өлімге ұшырайды. Емізетін мегежіндерде агалактия байқалуы мүмкін. Ауырып жазылған мегежіндер бактерия тасымалдаушылар болып келеді.
2. 6. Патологоанатомиялық өзгерістер.
Сальмонеллез - жұқпалы ішек ауруы. Адамдарға Сальмонеллез әр түрлі үй жануарлары мен құстардан жұғады. Ауру, әсіресе, нәрестелер мен қарт адамдарда ауыр өтеді. Ауруды лабораторияда арнайы бактериол (қан, нәжіс, құсық қалдығы, т. б. алынады) және серол. әдіспен (Видаль реакциясы, т. б. ) анықтайды.
Сальмонеллез барлық үй түліктерінің төлдерінің Salmonella микробтары тудыратын септицемия және токсемия нышандарымен, ішек-қарынның, тыныс мүшелерінің зақымдануымен сипатталатын, қой мен биеде, сирегірек сиырда іш тастаумен білінетін инфекциялық ауру. Құстарда бұл ауруды пуллороз деп атайды және оның негізгі белгілерінің бірі іш өту, саңғырығының аппақ болуы. Ересек құстарда бұл ауруды сүзек деп атайды.
Торай сальмонеллезі ас қорыту, тыныс алу мүшелерінің, тамырлар мен қан түзілетін жүйенің зақымдануымен сипатталады. Ауруға 5 айға дейінгі торайлар ауырады, емшектегі торайларда сирек кездеседі. Энзоотия сипатында өтеді. Маусымдылық байқалмайды. Жас торайлар арасында шығын 10-90% аралығында болады. Ауру септициямен, жіті немесе созылмалы энтеритпен сипатталады.
Қоздырушылары - Salmonella cholera suis пен Salmonella typhi suis, сирегірек - Salmonella typhimurium мен Salmonella dublin, т. б.
... жалғасы- Іс жүргізу
- Автоматтандыру, Техника
- Алғашқы әскери дайындық
- Астрономия
- Ауыл шаруашылығы
- Банк ісі
- Бизнесті бағалау
- Биология
- Бухгалтерлік іс
- Валеология
- Ветеринария
- География
- Геология, Геофизика, Геодезия
- Дін
- Ет, сүт, шарап өнімдері
- Жалпы тарих
- Жер кадастрі, Жылжымайтын мүлік
- Журналистика
- Информатика
- Кеден ісі
- Маркетинг
- Математика, Геометрия
- Медицина
- Мемлекеттік басқару
- Менеджмент
- Мұнай, Газ
- Мұрағат ісі
- Мәдениеттану
- ОБЖ (Основы безопасности жизнедеятельности)
- Педагогика
- Полиграфия
- Психология
- Салық
- Саясаттану
- Сақтандыру
- Сертификаттау, стандарттау
- Социология, Демография
- Спорт
- Статистика
- Тілтану, Филология
- Тарихи тұлғалар
- Тау-кен ісі
- Транспорт
- Туризм
- Физика
- Философия
- Халықаралық қатынастар
- Химия
- Экология, Қоршаған ортаны қорғау
- Экономика
- Экономикалық география
- Электротехника
- Қазақстан тарихы
- Қаржы
- Құрылыс
- Құқық, Криминалистика
- Әдебиет
- Өнер, музыка
- Өнеркәсіп, Өндіріс
Қазақ тілінде жазылған рефераттар, курстық жұмыстар, дипломдық жұмыстар бойынша біздің қор #1 болып табылады.



Ақпарат
Қосымша
Email: info@stud.kz